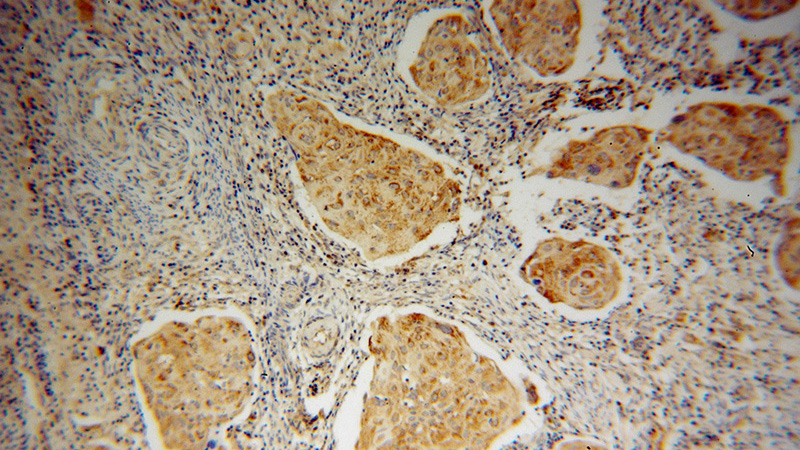
Immunohistochemical of paraffin-embedded human cervical cancer using Catalog No:107807(ABCG1 antibody) at dilution of 1:100 (under 10x lens)

-
Product Name
ABCG1 antibody
- Documents
-
Description
ABCG1 Rabbit Polyclonal antibody. Positive IP detected in mouse brain tissue. Positive WB detected in multi-cells/tissue, HeLa cells, Jurkat cells, mouse brain tissue, mouse lung tissue, RAW264.7 cells. Positive IHC detected in human cervical cancer tissue, human tonsillitis tissue. Observed molecular weight by Western-blot: 60-65kd
-
Tested applications
ELISA, IHC, WB, IP
-
Species reactivity
Human,Mouse,Rat; other species not tested.
-
Alternative names
ABC8 antibody; ABCG1 antibody; White protein homolog antibody; WHITE1 antibody; WHT1 antibody
-
Isotype
Rabbit IgG
-
Preparation
This antibody was obtained by immunization of ABCG1 recombinant protein (Accession Number: NM_016818). Purification method: Antigen affinity purified.
-
Clonality
Polyclonal
-
Formulation
PBS with 0.02% sodium azide and 50% glycerol pH 7.3.
-
Storage instructions
Store at -20℃. DO NOT ALIQUOT
-
Applications
Recommended Dilution:
WB: 1:500-1:5000
IP: 1:500-1:5000
IHC: 1:20-1:200
-
Validations

WB result of Catalog No:(ABCG1 antibody) on multiple lysates.
Immunohistochemical of paraffin-embedded human cervical cancer using Catalog No:107807(ABCG1 antibody) at dilution of 1:100 (under 10x lens)

Immunohistochemical of paraffin-embedded human cervical cancer using Catalog No:107807(ABCG1 antibody) at dilution of 1:100 (under 40x lens)

IP Result of anti-ABCG1 (IP:Catalog No:107807, 4ug; Detection:Catalog No:107807 1:1000) with mouse brain tissue lysate 4000ug.
-
Background
ABCG1 represents ATP-binding cassette, sub-family G (WHITE), member 1
-
References
- Xue J, Wang C, Zhu C, Li Y. ATP-binding cassette transporter G1 protects against endothelial dysfunction induced by high glucose. Diabetes research and clinical practice. 101(1):72-80. 2013.
- Xue J, Wei J, Dong X. ABCG1 deficiency promotes endothelial apoptosis by endoplasmic reticulum stress-dependent pathway. The journal of physiological sciences : JPS. 63(6):435-44. 2013.
- Hao S, Ji J, Zhao H. Mitochondrion-Targeted Peptide SS-31 Inhibited Oxidized Low-Density Lipoproteins-Induced Foam Cell Formation through both ROS Scavenging and Inhibition of Cholesterol Influx in RAW264.7 Cells. Molecules (Basel, Switzerland). 20(12):21287-97. 2015.
- Zhang L, Jiang M, Shui Y. DNA topoisomerase II inhibitors induce macrophage ABCA1 expression and cholesterol efflux-an LXR-dependent mechanism. Biochimica et biophysica acta. 1831(6):1134-45. 2013.
Related Products / Services
Please note: All products are "FOR RESEARCH USE ONLY AND ARE NOT INTENDED FOR DIAGNOSTIC OR THERAPEUTIC USE"
